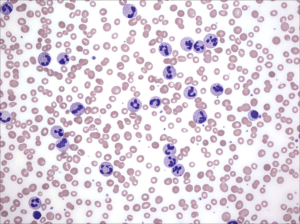

- Archaeology
- Astronomy
- Biology
- Chemistry
- Computer Science
- General Science
- Math
- Medical
- Meteorology
- Physics
- Special topics
Archaeology
Astronomy
Biology
- What is this? 049

- What is this? 048

- What is this? 047

- What is this? 038

- What is this? 033

- What is this? 031

- What is this? 030

- What is this? 029

- What is this? 022

- What is this? 013

- What is this? 010

- What is this? 009

- What is this? 004

- What is this? 001

Chemistry
- What is this? 052

- What is this? 048

- What is this? 046

- What is this? 042

- What is this? 040

- What is this? 037

- What is this? 035

- What is this? 028

- What is this? 019

- What is this? 017

- What is this? 015

- What is this? 010

Computer Science
General Science
Math
- What is this? 053

- What is this? 032

- What is this? 027

- What is this? 025

- What is this? 021

- What is this? 018

- What is this? 011

- What is this? 007

Medical
- What is this? 049

- What is this? 047

- What is this? 043

- What is this? 038

- What is this? 031

- What is this? 022

- What is this? 016

- What is this? 012

- What is this? 009
- What is this? 001

Meteorology
Physics
- What is this? 050

- What is this? 041

- What is this? 034

- What is this? 026

- What is this? 025

- What is this? 023

- What is this? 019

- What is this? 015

- What is this? 011

- What is this? 008

Special topics
Anatomy
Exponents and Logarithms
Greek Symbols
- What is this? 032

- What is this? 025

- What is this? 011

- What is this? 008

- What is this? 003

- What is this? 002

Maps
Scientific Notation
Units
- What is this? 041

- What is this? 027

- What is this? 020

- What is this? 019

- What is this? 015

- What is this? 011







